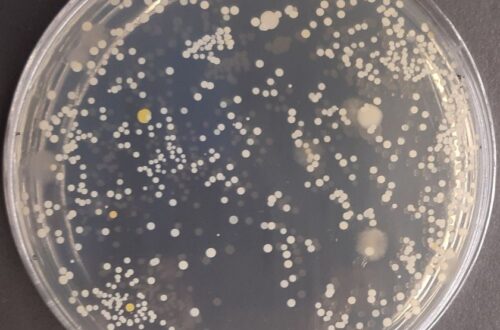

Populiariausio socialinio tinklo pasaulyje „Facebook“ vartotojų skaičius viršijo 2,9 mlrd., o kasdien jų sugeneruojamų duomenų kiekis siekia 4 mln. gigabaitų. Nenuostabu, kad tai tapo ne vien vieta bendrauti, bet ir terpė skleisti ir naudingą informaciją, ir dezinformaciją. Minesotos Duluto universiteto tyrėjas Joshas Fergenas teigia, kad šiandien „Facebook“ yra vienas didžiausių klaidinančio turinio apie atsinaujinančią energetiką skleidėjų. Kaip socialiniai tinklai veikia gyventojų nuomonę ir kodėl sekame paskui minią, atsakymo ieško tiek psichologai, tiek atsinaujinančios energetikos šalininkai.
Psichologė psichoterapeutė Sonata Vizgaudienė tikina, kad žmogaus polinkis būti minioje yra evoliuciškai įgytas – visais laikais buvo lengviau išgyventi taip nei pavieniui.
„Šiandien norime būti su minia ne vien dėl saugumo jausmo. Tai gali būti siekis būti šalia tų, kurie yra stipresni ar protingesni. Jei esu tarp tų, kurie kažką žino, vadinasi, kyla ir mano paties savivertė – „esu ne ką prastesnis“. Minios principas yra svarbus ir bendražmogiškas, tuo naudojasi ir nuomonių formuotojai: paskleidus žinią pakanka, kad bent dalis sekėjų ja įtikėtų, jog įvyktų sniego gniūžtės efektas“, – komentuoja ji.
Pritarti kitų žmonių nuomonei taip pat yra natūralus reiškinys. Pasak psichologės, apie 80 proc. žmonių yra konformistai (linkę prisitaikyti) ir tik likusioji dalis linkusi labiau prieštarauti bei nesutikti. Vis dėlto, eiti prieš minią nėra lengva.
„Jei žmogus socialiniame tinkle gauna informacijos, kuri neatitinka jo aplinkos nuomonės, reikalauja didesnio įsigilinimo ir faktų patikrinimo, jam gali būti nejauku tokia informacija dalintis – baiminamasi priešingų reakcijų, minios užpuolimo. Niekas nenori būti atstumtas. Tik maištautojo, lyderio savybes turintis žmogus gali be baimės prieštarauti daugumos nuomonei“, – aiškina S. Vizgaudienė.
Dėl šios priežasties socialinių tinklų vartotojai yra linkę sekti autoritetais – jais tampa ne vien nuomonių formuotojai, bet ir artimos aplinkos žmonės, kuriais pasitikima ir tikima. O priimti kito nuomonę yra kur kas lengviau, nei patiems gilintis konkrečia tema, teigia psichologė: „Gyvenimo tempas dabar toks, kad esame visa ko greitai vartotojai – neturime nei laiko, nei jėgų patikrinti visą informacijos srautą, kurį kasdien gauname“.
Kova prieš vėjo jėgaines – naudinga ir Rusijai
Prieš kelerius metus Lietuvos vėjo elektrinių asociacijos (LVEA) organizuotos apklausos duomenimis, didžioji dauguma šalies gyventojų palaiko atsinaujinančią energetiką – 82 proc. respondentų pritaria vėjo energetikos plėtrai. Pasak LVEA direktorės Urtės Daškevičiūtės, reprezentatyvios šalies gyventojų apklausos rodo teigiamą požiūrį į vėjo jėgaines, tačiau socialiniame tinkle „Facebook“ apstu grupių, kuriose vėjo energetikos priešininkai savo pasisakymais siekia paveikti ir suklaidinti visuomenę.
„Jie garsiai rėkia, pasitelkia dramatiškus pavyzdžius, istorijas, jas pagražina. Į tokias grupes užsukus, nesunku suklysti ir pagalvoti, kad galbūt iš tiesų lietuviai nenori matyti vėjo jėgainių, tačiau daugeliu atveju, jei atidžiau paanalizuotume, kas, ką ir kaip kalba, pamatytume, kad komunikuojama tendencingai – dažniausiai kalba nedidelė tų pačių asmenų grupė, jie diskutuoja tarpusavyje kurdami masių įspūdį ir taip bando į pokalbį įtraukti kitus. Jie puikūs dezinformacijos skleidėjai“, – pažymi U. Daškevičiūtė.
U. Daškevičiūtei antrina Lietuvos atsinaujinančių išteklių energetikos konfederacijos prezidentas Martynas Nagevičius, aktyviai apie energetikos sektorių komunikuojantis savo asmeninėje paskyroje. Nors ir jo paties socialinio tinklo rate susidaro įspūdis, kad palaikančių vėjo energetiką yra dauguma, po savo įrašais jis sulaukia ir kardinaliai priešingų nuomonių.
„Dažniausiai kyla diskusijos dėl vėjo elektrinių poveikio kraštovaizdžiui – gražu ar negražu tolumoje besisukančios jėgainės. Tai visiškai subjektyvi tema, kur sunku ginčytis ir bandyti pakeisti oponento nuomonę. Taip pat keliamos įvairios versijos apie vėjo jėgainių daromą žalą žmonių sveikatai, naminiams gyvūnams, nekilnojamojo turto vertei. Tenka remtis įvairiomis Pasaulio sveikatos organizacijos ataskaitomis, reprezentatyviais tyrimais, norint argumentuoti tokioje diskusijoje“, – pasakoja M. Nagevičius, neslepiantis, kad toks visuomenės švietimas reikalauja daug kantrybės.
Pašnekovo teigimu, Lietuvoje itin paplitęs neigiamas požiūris į verslą skatina žmones ieškoti įvairių kliūčių, kodėl neturėtų būti plėtojami vėjo jėgainių parkai – neigiamas nusiteikimas neretai nuslopsta, kai vietos bendruomenės sulaukia ilgalaikės finansinės paramos iš parkų vystytojų.
„Socialiniuose tinkluose pasitaiko diskusijų ir dėl nepakankamo vėjo energetikos žalumo. Baksnojama į vėjo jėgainių gamybos metu išskiriamą anglies dvideginį (CO2), nors per pirmuosius jėgainės eksploatavimo metus jo daugiau sutaupoma nei išskiriama. Kyla nepasitenkinimas dėl neperdirbamų jėgainių menčių, nors judama šios problemos sprendimo link, jau turime sėkmingų pavyzdžių, kaip šios mentės yra pritaikomos ir panaudojamos kitose srityse“, – vardina M. Nagevičius.
Pasak jo, tarp skleidžiamos dezinformacijos apie vėjo energetikos neva daromą žalą netrūksta rusiškų šaltinių, atspindinčių Rusijos formuojamą naratyvą – vėjo energetika yra kenksminga šios šalies ekonomikai, daugiausiai uždirbančiai iš iškastinio kuro tiekimo kitoms šalims.
Savisaugos instinktas skatina domėtis negatyviomis naujienomis
Skandalingi pareiškimai socialiniuose tinkluose apie vėjo jėgainių neigiamą poveikį neretai lydimi šokiruojančiais vaizdais – vėjo jėgainių menčių kapinynais, degančiomis vėjo jėgainėmis, sergančių žmonių nuotraukomis ir panašiai.
„Iš prigimties žmonės yra smalsūs, todėl neretai susidomi net absurdiškomis antraštėmis – prigimtinis smalsumas verčia mus skaityti įvairias naujienas, nors patys suprantame, kad tai, kas parašyta, gali būti nesąmonė. O jei tokią naujieną dar lydi nuotraukos su mums artimomis gyvenimiškomis situacijomis, mūsų emocijos yra sužadinamos ir didesnė tikimybė, kad priimsime dezinformaciją kaip tiesą“, – sako psichologė S. Vizgaudienė.
Bandymus paveikti žmonių nuomonę, ja manipuliuoti galima atpažinti ne vien iš dėmesį traukiančių antraščių ir šokiruojančių vaizdų – tam pasitelkiami ir jautrūs klausimai.
„Ypač jautriai reaguojame į tai, kas mums asmeniškai aktualu, bet klausimai, susiję su sveikata, vaikais, tarša gamtai veikia daugumą žmonių. Tokiais atvejais matydami negatyvią informaciją esame labiau linkę ja patikėti ir dalintis su kitais savo socialinio tinklo burbule“, – komentuoja S. Vizgaudienė.
Pasak jos, žmonių polinkis domėtis negatyvia informacija taip pat yra evoliucijos pasekmė – reaguodami į negatyvias naujienas instinktyviai siekiame pasiruošti blogiausiam ir apsaugoti save bei savo artimuosius nuo galimos nelaimės.
Kovojant su oponentais verta nepamiršti pagarbos
Ar verta įsitraukti į diskusijas socialiniuose tinkluose su vėjo energetikos priešininkais, vienareikšmio atsakymo nėra. M. Nagevičiaus nuomone, visuomenės nuomonė gali keistis iš lėto tik skaitant patikimus šaltinius ir pagarbiai diskutuojant.
„Stumdami priešingą nuomonę turinčius žmones į nuošalį tik auginame stiprius oponentus ir leidžiame formuotis naujoms visuomenės grupėms. Pavyzdžiui, kovodami su skiepų priešininkais sukūrėme antivakserių grupę, kurią nuo savęs nustūmėme. Būna žmonių, kuriems norisi eiti prieš daugumos nuomonę, būti mažumoje. Jie įsijaučia į kovą įvairiomis temomis – vėjo jėgainės tėra viena jų – ir tai tampa jų kasdiene misija. Jei iš jų pradedame šaipytis, vadinti kvailiais, tarnaujantiems Rusijai, konfrontaciją tarp skirtingų nuomonių tik padidiname“, – įsitikinęs Lietuvos atsinaujinančių išteklių energetikos konfederacijos prezidentas.
Psichologė S. Vizgaudienė tvirtina, kad skleisti patikimą informaciją reikėtų ne diskusijose komentarų forma, bet tiesiog dalinantis naujienomis ir nuorodomis savo socialinių tinklų paskyrose – kuo daugiau bus teisingos informacijos, tuo didesni šansai, kad realūs faktai nugalės dezinformaciją, o konkrečios idėjos skeptikai ir kritikai galiausiai taps jos sąjungininkais ir rėmėjais.
„Jei kovosime per komentarus socialiniuose tinkluose, greičiausiai įsivelsime į beprasmį apsimėtymą aštriais teiginiais, įsiaudrinsime ir pasikrausime negatyvo. Turime suprasti, kad komentarai yra labiau žaidimo forma, o ne faktinės, realios ir patikimos informacijos gavimo bei apsikeitimo būdas. Vieni įsivelia į diskusijas socialiniuose tinkluose siekdami formuoti nuomonę, kiti – pasijausti svarbūs ir gauti dėmesio, tretiems – tai būdas nuleisti garą ir išsiventiliuoti. Diskutuodami su nepažįstamais žmonėmis galime nežinoti, kokių tikslų vedini jie tai daro“, – sako ji.
Pranešimą paskelbė: Sigita Macanko, UAB „Idea Prima”